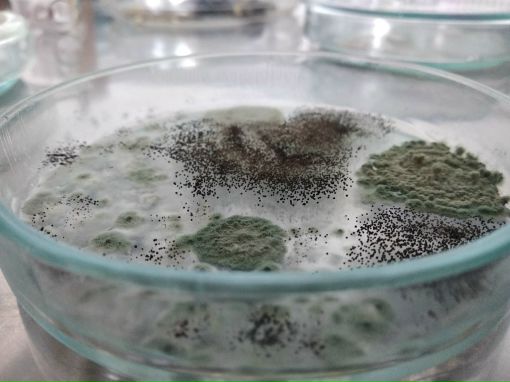

Как освободить свою посуду от плесени: проверенные способы и советы
Плесень на посуде может быть не только неприятным зрелищем, но и опасным для здоровья. Чтобы избавиться от плесени на посуде и предотвратить ее повторное появление, следуйте этим полезным советам.



Очистите посуду от плесени моющим средством с антибактериальными свойствами.
КАК НАВСЕГДА УБРАТЬ ПЛЕСЕНЬ ГРИБОК в ванной КАК ОЧИСТИТЬ ШВЫ МЕЖДУ ПЛИТКОЙ УДИВИТЕЛЬНО ПРОСТО

Используйте воду с добавлением щелочи, чтобы убрать плесень с посуды.
Как я легко удаляю плесень надолго.

Посуду, пораженную плесенью, можно подвергнуть обработке горячей водой с добавлением соды и средства для мытья посуды.
Как убрать ГРИБОК ПЛЕСЕНЬ Как избавиться от ЗАТХЛОГО ЗАПАХА.

Пользуйтесь специальными средствами для борьбы с плесенью на посуде.
1 ТАБЛЕТКА и ЧЕРНОЙ ПЛЕСЕНИ на окнах не будет НИКОГДА
Промойте посуду в горячей воде с добавлением уксуса для тщательной дезинфекции.
В посудосушке сырость и плесень......


Периодически проверяйте посуду на наличие плесени и удаляйте ее при первых признаках.
Как избавиться от плесени народными средствами
Избегайте хранения посуды в темных и влажных местах, чтобы предотвратить появление плесени.
Хотела сделать лайфхак по удалению плесени с силиконовой вещицы на кухне и потерпела фиаско


Посуду, подверженную плесени, лучше вымыть отдельно от остальной посуды, чтобы избежать распространения спор плесени.
Как ОТМЫТЬ ПОДСТАВКУ ДЛЯ СТОЛОВЫХ ПРИБОРОВ от налета, плесени. Чистим сушилку для ложек и вилок
Стерилизация и дезинфекция посуды и инструментов для домашней косметики

После очистки и дезинфекции посуды, тщательно просушите ее перед хранением.
КАК НАВСЕГДА УНИЧТОЖИТЬ ГРИБОК И ПЛЕСЕНЬ В ПОГРЕБЕ ИЛИ ПОДВАЛЕ ПОДРУЧНЫМИ СРЕДСТВАМИ
Постоянно поддерживайте чистоту и сухость в помещении, где хранится посуда, чтобы предотвратить появление плесени.
